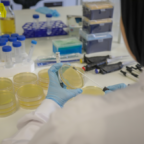

(PRESSEMITTEILUNG) LENDELEDE, Belgien, 7. Februar 2026 — /EuropaWire/ — EPP Pricing Platform BV („EPP“), die globale, gemeinnützige Organisation, die sich der Weiterentwicklung des Pricing- und Revenue Growth Management (RGM)-Berufs verschrieben hat, hat heute einen Führungswechsel im Rahmen ihrer langfristigen Weiterentwicklung … Read the full press release